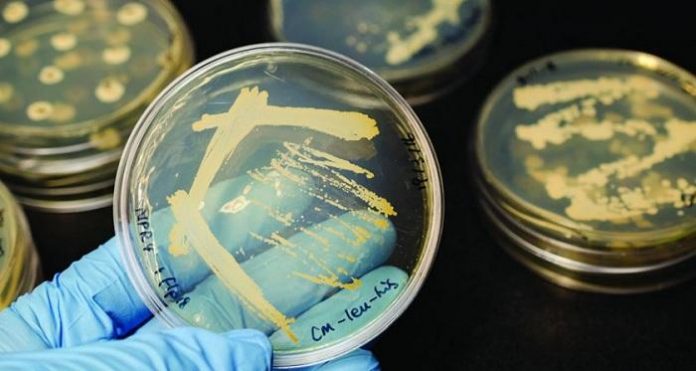
бактерии бактерии

Австралийски и японски специалисти проектираха наномрежа със златно покритие, която убива резистентни бактерии и е алтернатива на хапчетата или иглите, съобщава Юрик алърт.
„Ако антибиотиците се доставят точно на мястото, където са най-необходими, ще могат да се прилагат по-малки количества от тях. Това означава по-малко странични ефекти и по-ниска вероятност бактериите да развият резистентност към лекарствата“, обясняват учените.
Разработката – плод на сътрудничеството между учени от университета „Флиндърс“ в Австралия и японския Национален институт по материалознание, е предназначена да се прилага или имплантира на инфектирани места. Материалът е направен от биосъвместим и биоразградим полимер, известен като поликапролактон, към който се добавят антибиотици и електрически заредени златни наночастици, докато все още е в течно състояние“.
В лабораторни тестове дискове от наномрежата са били поставени в блюда на Петри заедно с популации на вредните бактерии от E. coli. За период от 14 дни антибиотиците постепенно се освобождават от мрежата, докато тя се разгражда, убивайки микробите.
„Въпреки че дозата е намалена в сравнение с тази за перорален прием, концентрацията на антибиотици, доставени до мястото на инфекцията, е достатъчно висока, за да се гарантира, че бактериите не могат да оцелеят. Това ще намали случаите на резистентност“, казва Инго Кьопер от изследователския екип от университета „Флиндърс“.